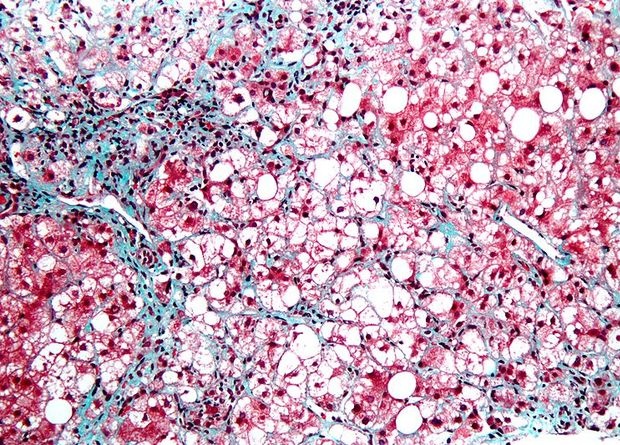

Технологию CAR-T применили для борьбы со старением клеток в легких и печени
Американские ученые впервые использовали Т-лимфоциты для борьбы с сенесцентными клетками, появление которых сопровождает старение тканей. Для этого они воспользовались технологией CAR-T: модифицировали иммунные клетки так, чтобы они распознавали распространенный на поверхности сенесцентных клеток белок. Метод оказался эффективен не только in vitro, но и in vivo, и улучшил состояние мышей при фиброзе легких и печени, а также при стеатогепатите. Кроме того, в минимальных дозах он не вызвал никаких побочных эффектов. Исследование опубликовано в журнале Nature.
Сенесцентные клетки, которые накапливаются в тканях при старении, во многом напоминают опухолевые. Они точно так же не выполняют своих основных функций в ткани, но вместо этого запускают перестройку межклеточного вещества, и в них точно так же заблокированы механизмы клеточного самоубийства — апоптоза.
Поэтому в качестве сенолитиков — препаратов, которые призваны очистить ткань от старых клеток — тестируют некоторые противоопухолевые лекарства, так как они действуют избирательно на клетки с заблокированным апоптозом. В отдельных экспериментах сенолитики уже показали свою способность продлевать жизнь мышам и улучшать (правда, пока незначительно) состояние людей с разными возрастными заболеваниями, например, воспалением суставом, фиброзом легких и диабетом.
Корина Амор (Corina Amor) вместе с коллегами из Мемориального онкологического центра имени Слоуна-Кеттеринга в Нью-Йорке предложили использовать противать сенесцентных клеток еще одно оружие, изначально придуманное для борьбы с раком, — технологию CAR-T (подробнее об этой технологии читайте в нашем материале «Химера против рака»). Это генетически модифицированные Т-лимфоциты, которые экспрессируют ген химерного рецептора, то есть запрограммированы распознавать конкретную молекулу на поверхности клеток и уничтожать ее носителя.
